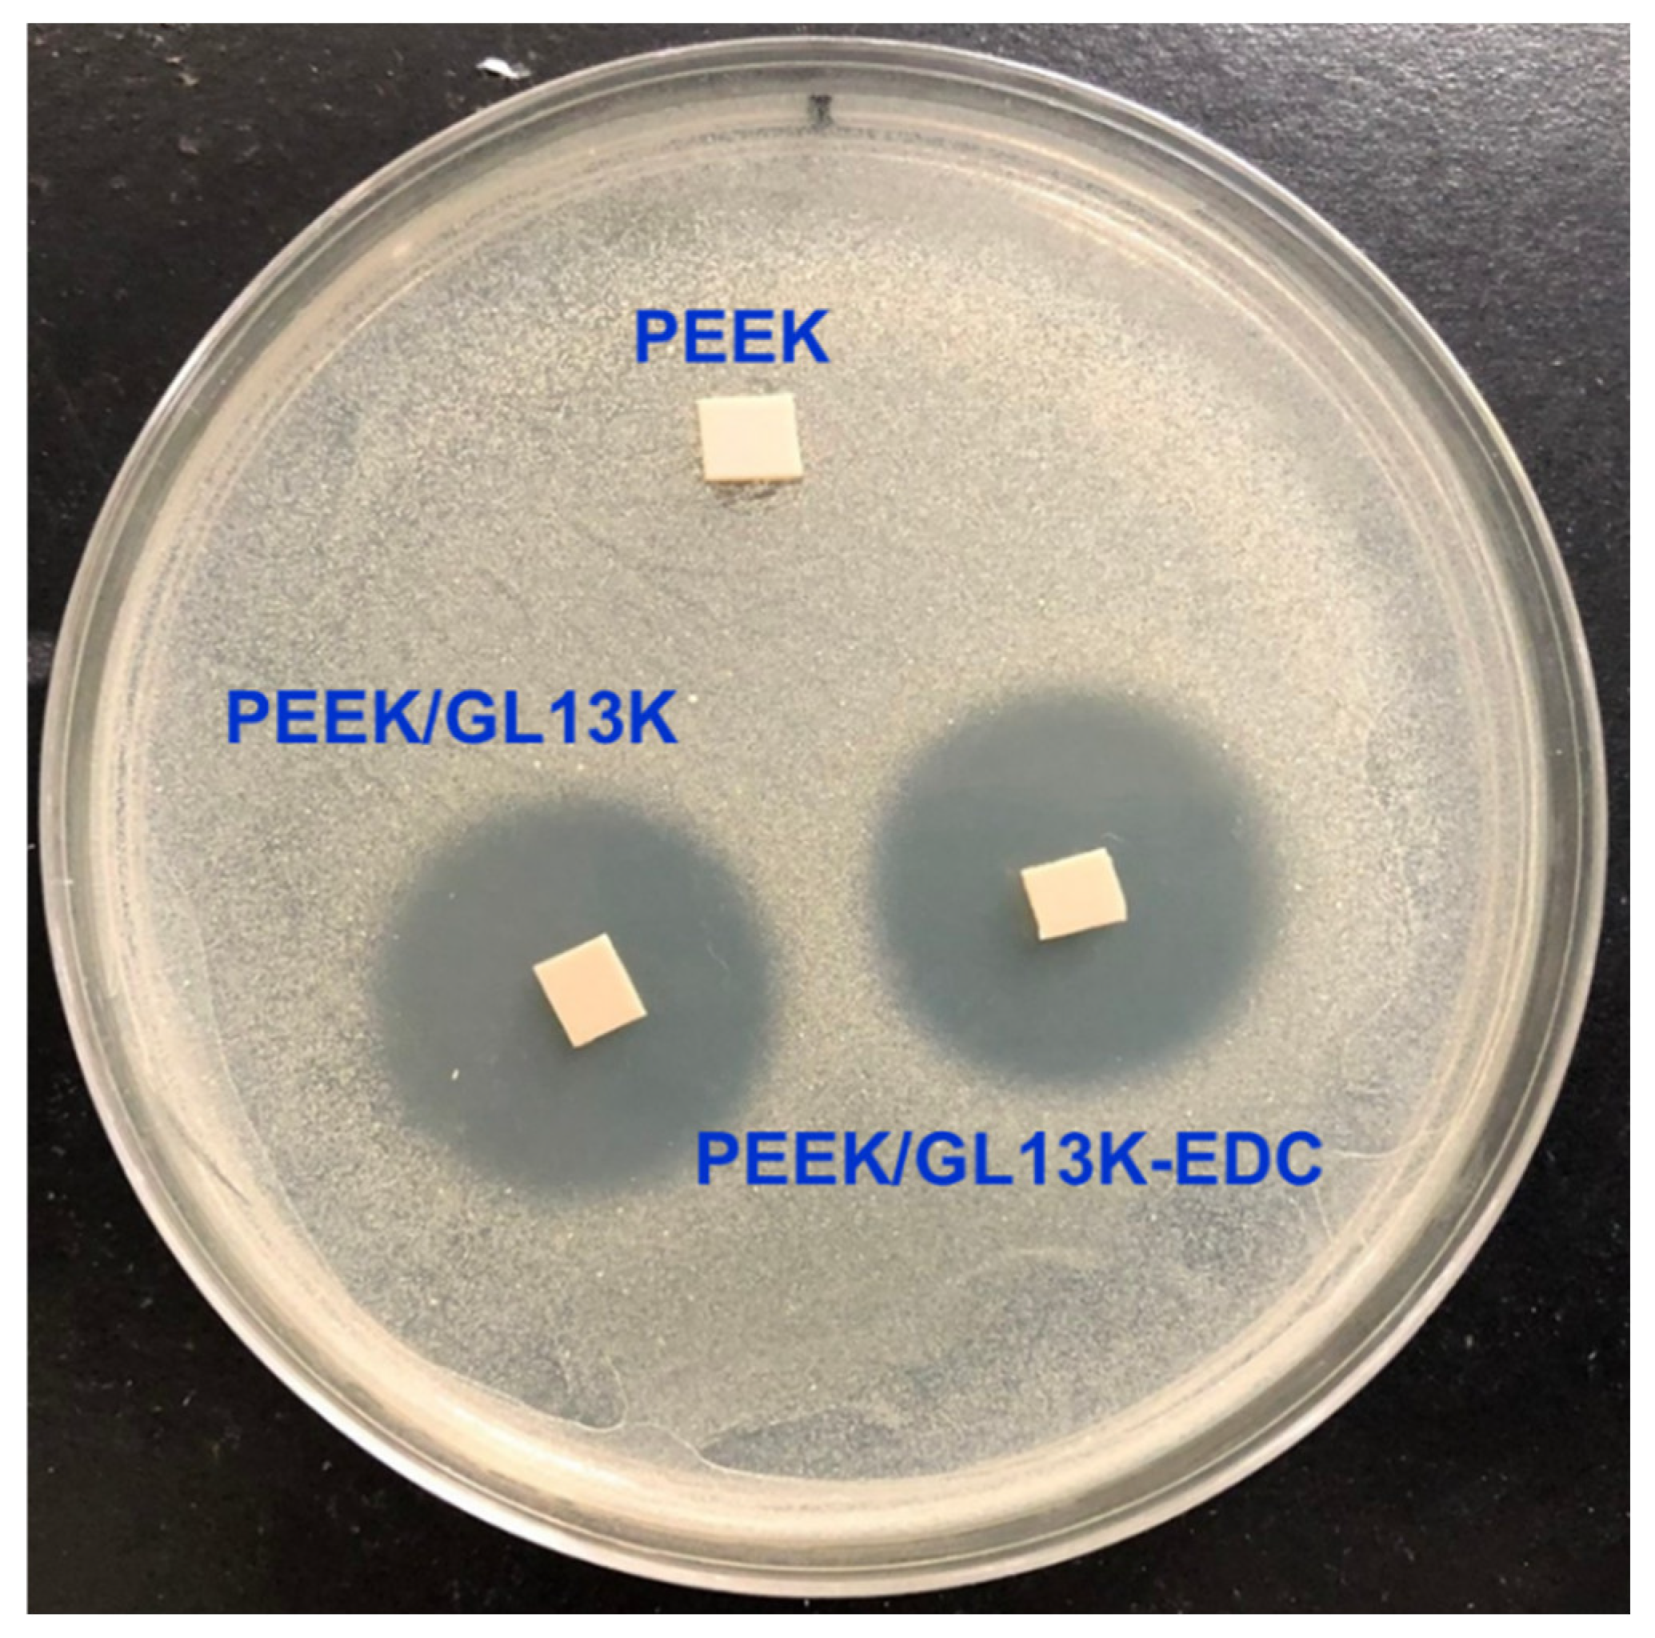
Ijms 23 00359 g005

Facilitating GL13K Peptide Grafting on Polyetheretherketone via 1-Ethyl-3-(3-dimethylaminopropyl)carbodiimide: Surface Properties and Antibacterial Activity
Abstract
:1. Introduction
2. Results and Discussion
2.1. Morphological Analysis
2.2. Surface Properties
2.3. Chemical Composition Analysis
2.4. Antibacterial Studies
2.5. Post-Bacterial Analysis
2.6. Peptide Coating Stability
3. Materials and Methods
3.1. Preparation of PEEK/GL13K-EDC
3.2. Characterizations of Composite Samples
3.3. Agar Diffusion Assay for Antibacterial Studies
4. Conclusions
Supplementary Materials
Author Contributions
Funding
Institutional Review Board Statement
Informed Consent Statement
Data Availability Statement
Acknowledgments
Conflicts of Interest
References
- Joung, Y.-H. Development of implantable medical devices: From an engineering perspective. Int. Neurourol. J. 2013, 17, 98–106. [Google Scholar] [CrossRef] [PubMed]
- Kadambi, P.; Luniya, P.; Dhatrak, P. Current advancements in polymer/polymer matrix composites for dental implants: A systematic review. Mater. Today Proc. 2021, 46, 740–745. [Google Scholar] [CrossRef]
- Shekhawat, D.; Singh, A.; Bhardwaj, A.; Patnaik, A. A Short Review on Polymer, Metal and Ceramic Based Implant Materials. IOP Conf. Ser. Mater. Sci. Eng. 2021, 1017, 12038. [Google Scholar] [CrossRef]
- Toh, H.W.; Toong, D.W.Y.; Ng, J.C.K.; Ow, V.; Lu, S.; Tan, L.P.; Wong, P.E.H.; Venkatraman, S.; Huang, Y.; Ang, H.Y. Polymer blends and polymer composites for cardiovascular implants. Eur. Polym. J. 2021, 146, 110249. [Google Scholar] [CrossRef]
- Verma, S.; Sharma, N.; Kango, S.; Sharma, S. Developments of PEEK (Polyetheretherketone) as a biomedical material: A focused review. Eur. Polym. J. 2021, 147, 110295. [Google Scholar] [CrossRef]
- Yu, Y.-H.; Liu, S.-J. Polyetheretherketone for orthopedic applications: A review. Curr. Opin. Chem. Eng. 2021, 32, 100687. [Google Scholar] [CrossRef]
- He, M.; Huang, Y.; Xu, H.; Feng, G.; Liu, L.; Li, Y.; Sun, D.; Zhang, L. Modification of polyetheretherketone implants: From enhancing bone integration to enabling multi-modal therapeutics. Acta Biomater. 2021, 129, 18–32. [Google Scholar] [CrossRef]
- Porrelli, D.; Mardirossian, M.; Crapisi, N.; Urban, M.; Ulian, N.A.; Bevilacqua, L.; Turco, G.; Maglione, M. Polyetheretherketone and titanium surface treatments to modify roughness and wettability—Improvement of bioactivity and antibacterial properties. J. Mater. Sci. Technol. 2021, 95, 213–224. [Google Scholar] [CrossRef]
- Kurtz, S.M.; Devine, J.N. PEEK biomaterials in trauma, orthopedic, and spinal implants. Biomaterials 2007, 28, 4845–4869. [Google Scholar] [CrossRef] [Green Version]
- Brum, R.S.; Labes, L.G.; Volpato, C.Â.M.; Benfatti, C.A.M.; Pimenta, A.L. Strategies to Reduce Biofilm Formation in PEEK Materials Applied to Implant Dentistry—A Comprehensive Review. Antibiotics 2020, 9, 609. [Google Scholar] [CrossRef]
- Krätzig, T.; Mende, K.C.; Mohme, M.; von Kroge, S.; Stangenberg, M.; Dreimann, M.; Westphal, M.; Weisselberg, S.; Eicker, S.O. Bacterial adhesion characteristics on implant materials for intervertebral cages: Titanium or PEEK for spinal infections? Eur. Spine J. 2021, 30, 1774–1782. [Google Scholar] [CrossRef]
- Ishihama, H.; Ishii, K.; Nagai, S.; Kakinuma, H.; Sasaki, A.; Yoshioka, K.; Kuramoto, T.; Shiono, Y.; Funao, H.; Isogai, N. An antibacterial coated polymer prevents biofilm formation and implant-associated infection. Sci. Rep. 2021, 11, 1–12. [Google Scholar] [CrossRef]
- Delaney, L.J.; MacDonald, D.; Leung, J.; Fitzgerald, K.; Sevit, A.M.; Eisenbrey, J.R.; Patel, N.; Forsberg, F.; Kepler, C.K.; Fang, T. Ultrasound-triggered antibiotic release from PEEK clips to prevent spinal fusion infection: Initial evaluations. Acta Biomater. 2019, 93, 12–24. [Google Scholar] [CrossRef]
- Chen, X.; Hirt, H.; Li, Y.; Gorr, S.-U.; Aparicio, C. Antimicrobial GL13K peptide coatings killed and ruptured the wall of Streptococcus gordonii and prevented formation and growth of biofilms. PLoS ONE 2014, 9, e111579. [Google Scholar] [CrossRef] [Green Version]
- Yuan, X.; Ouyang, L.; Luo, Y.; Sun, Z.; Yang, C.; Wang, J.; Liu, X.; Zhang, X. Multifunctional sulfonated polyetheretherketone coating with beta-defensin-14 for yielding durable and broad-spectrum antibacterial activity and osseointegration. Acta Biomater. 2019, 86, 323–337. [Google Scholar] [CrossRef] [PubMed]
- De Breij, A.; Riool, M.; Kwakman, P.H.S.; de Boer, L.; Cordfunke, R.A.; Drijfhout, J.W.; Cohen, O.; Emanuel, N.; Zaat, S.A.J.; Nibbering, P.H.; et al. Prevention of Staphylococcus aureus biomaterial-associated infections using a polymer-lipid coating containing the antimicrobial peptide OP-145. J. Control. Release 2016, 222, 1–8. [Google Scholar] [CrossRef] [PubMed]
- Meng, X.; Zhang, J.; Chen, J.; Nie, B.; Yue, B.; Zhang, W.; Lyu, Z.; Long, T.; Wang, Y. KR-12 coating of polyetheretherketone (PEEK) surface via polydopamine improves osteointegration and antibacterial activity in vivo. J. Mater. Chem. B 2020, 8, 10190–10204. [Google Scholar] [CrossRef] [PubMed]
- Yang, W.; Gondil, V.S.; Luo, D.; He, J.; Wei, H.; Yang, H. Optimized Silica-Binding Peptide-Mediated Delivery of Bactericidal Lysin Efficiently Prevents Staphylococcus aureus from Adhering to Device Surfaces. Int. J. Mol. Sci. 2021, 22, 12544. [Google Scholar] [CrossRef]
- Holmberg, K.V.; Abdolhosseini, M.; Li, Y.; Chen, X.; Gorr, S.-U.; Aparicio, C. Bio-inspired stable antimicrobial peptide coatings for dental applications. Acta Biomater. 2013, 9, 8224–8231. [Google Scholar] [CrossRef] [Green Version]
- Hirt, H.; Gorr, S.-U. Antimicrobial peptide GL13K is effective in reducing biofilms of Pseudomonas aeruginosa. Antimicrob. Agents Chemother. 2013, 57, 4903–4910. [Google Scholar] [CrossRef] [Green Version]
- Huang, Y.-T.; Kumar, S.R.; Chan, H.-C.; Jhan, Z.-H.; Chen, D.W.; Lue, S.J. Efficacy of antimicrobial peptides (AMPs) against Escherichia coli and bacteria morphology change after AMP exposure. J. Taiwan Inst. Chem. Eng. 2021, 126, 307–312. [Google Scholar] [CrossRef]
- Liu, Y.; Sun, Y.; Li, S.; Liu, M.; Qin, X.; Chen, X.; Lin, Y. Tetrahedral Framework Nucleic Acids Deliver Antimicrobial Peptides with Improved Effects and Less Susceptibility to Bacterial Degradation. Nano Lett. 2020, 20, 3602–3610. [Google Scholar] [CrossRef]
- Hirt, H.; Hall, J.W.; Larson, E.; Gorr, S.-U. A D-enantiomer of the antimicrobial peptide GL13K evades antimicrobial resistance in the Gram positive bacteria Enterococcus faecalis and Streptococcus gordonii. PLoS ONE 2018, 13, e0194900. [Google Scholar] [CrossRef] [Green Version]
- Ye, Z.; Zhu, X.; Mutreja, I.; Boda, S.K.; Fischer, N.G.; Zhang, A.; Lui, C.; Qi, Y.; Aparicio, C. Biomimetic mineralized hybrid scaffolds with antimicrobial peptides. Bioact. Mater. 2021, 6, 2250–2260. [Google Scholar] [CrossRef]
- Boda, S.K.; Fischer, N.G.; Ye, Z.; Aparicio, C. Dual Oral Tissue Adhesive Nanofiber Membranes for pH-Responsive Delivery of Antimicrobial Peptides. Biomacromolecules 2020, 21, 4945–4961. [Google Scholar] [CrossRef] [PubMed]
- Chen, X.; Zhou, X.C.; Liu, S.; Wu, R.F.; Aparicio, C.; Wu, J.Y. In vivo osseointegration of dental implants with an antimicrobial peptide coating. J. Mater. Sci. Mater. Med. 2017, 28, 76. [Google Scholar] [CrossRef] [PubMed]
- Zhou, L.; Han, Y.; Ding, J.; Chen, X.; Huang, S.; Xing, X.; Wu, D.; Chen, J. Regulation of an Antimicrobial Peptide GL13K-Modified Titanium Surface on Osteogenesis, Osteoclastogenesis, and Angiogenesis Base on Osteoimmunology. ACS Biomater. Sci. Eng. 2021, 7, 4569–4580. [Google Scholar] [CrossRef]
- Zhou, L.; Lin, Z.; Ding, J.; Huang, W.; Chen, J.; Wu, D. Inflammatory and biocompatibility evaluation of antimicrobial peptide GL13K immobilized onto titanium by silanization. Colloids Surf. B Biointerfaces 2017, 160, 581–588. [Google Scholar] [CrossRef] [PubMed]
- Zhou, L.; Lai, Y.; Huang, W.; Huang, S.; Xu, Z.; Chen, J.; Wu, D. Biofunctionalization of microgroove titanium surfaces with an antimicrobial peptide to enhance their bactericidal activity and cytocompatibility. Colloids Surf. B Biointerfaces 2015, 128, 552–560. [Google Scholar] [CrossRef] [PubMed]
- Yu, Y.; Sun, Y.; Zhou, X.; Mao, Y.; Liu, Y.; Ye, L.; Kuang, L.; Yang, J.; Deng, Y. Ag and peptide co-decorate polyetheretherketone to enhance antibacterial property and osteogenic differentiation. Colloids Surf. B Biointerfaces 2021, 198, 111492. [Google Scholar] [CrossRef]
- Gao, C.; Wang, Z.; Jiao, Z.; Wu, Z.; Guo, M.; Wang, Y.; Liu, J.; Zhang, P. Enhancing antibacterial capability and osseointegration of polyetheretherketone (PEEK) implants by dual-functional surface modification. Mater. Des. 2021, 205, 109733. [Google Scholar] [CrossRef]
- Xu, A.; Zhou, L.; Deng, Y.; Chen, X.; Xiong, X.; Deng, F.; Wei, S. A carboxymethyl chitosan and peptide-decorated polyetheretherketone ternary biocomposite with enhanced antibacterial activity and osseointegration as orthopedic/dental implants. J. Mater. Chem. B 2016, 4, 1878–1890. [Google Scholar] [CrossRef] [PubMed]
- Li, M.; Bai, J.; Tao, H.; Hao, L.; Yin, W.; Ren, X.; Gao, A.; Li, N.; Wang, M.; Fang, S.; et al. Rational integration of defense and repair synergy on PEEK osteoimplants via biomimetic peptide clicking strategy. Bioact. Mater. 2021, 8, 309–324. [Google Scholar] [CrossRef]
- Yin, W.; Chen, M.; Bai, J.; Xu, Y.; Wang, M.; Geng, D.; Pan, G. Recent advances in orthopedic polyetheretherketone biomaterials: Material fabrication and biofunction establishment. Smart Mater. Med. 2022, 3, 20–36. [Google Scholar] [CrossRef]
- Masamoto, K.; Fujibayashi, S.; Yabutsuka, T.; Hiruta, T.; Otsuki, B.; Okuzu, Y.; Goto, K.; Shimizu, T.; Shimizu, Y.; Ishizaki, C.; et al. In vivo and in vitro bioactivity of a “precursor of apatite” treatment on polyetheretherketone. Acta Biomater. 2019, 91, 48–59. [Google Scholar] [CrossRef] [PubMed]
- Qin, L.; Yao, S.; Zhao, J.; Zhou, C.; Oates, T.W.; Weir, M.D.; Wu, J.; Xu, H.H.K. Review on Development and Dental Applications of Polyetheretherketone-Based Biomaterials and Restorations. Materials 2021, 14, 408. [Google Scholar] [CrossRef] [PubMed]
- Zhou, H.; Goel, V.K.; Bhaduri, S.B. A fast route to modify biopolymer surface: A study on polyetheretherketone (PEEK). Mater. Lett. 2014, 125, 96–98. [Google Scholar] [CrossRef]
- Tran, N.; Kelley, M.N.; Tran, P.A.; Garcia, D.R.; Jarrell, J.D.; Hayda, R.A.; Born, C.T. Silver doped titanium oxide–PDMS hybrid coating inhibits Staphylococcus aureus and Staphylococcus epidermidis growth on PEEK. Mater. Sci. Eng. C 2015, 49, 201–209. [Google Scholar] [CrossRef] [PubMed]
- Yang, L.; Ohki, Y.; Hirai, N.; Hanada, S. Aging of poly (ether ether ketone) by heat and gamma rays—Its degradation mechanism and effects on mechanical, dielectric and thermal properties. Polym. Degrad. Stab. 2017, 142, 117–128. [Google Scholar] [CrossRef]
- Ha, S.-W.; Hauert, R.; Ernst, K.-H.; Wintermantel, E. Surface analysis of chemically-etched and plasma-treated polyetheretherketone (PEEK) for biomedical applications. Surf. Coat. Technol. 1997, 96, 293–299. [Google Scholar] [CrossRef]
- Reffuveille, F.; Josse, J.; Vallé, Q.; Gangloff, C.; Gangloff, S.C. Staphylococcus aureus Biofilms and their Impact on the Medical Field. Rise Virulence Antibiot. Resist. Staphylococcus Aureus 2017, 11, 187. [Google Scholar]
- Vashist, S.K. Comparison of 1-ethyl-3-(3-dimethylaminopropyl) carbodiimide based strategies to crosslink antibodies on amine-functionalized platforms for immunodiagnostic applications. Diagnostics 2012, 2, 23–33. [Google Scholar] [CrossRef] [PubMed] [Green Version]
- Gerard Wall, H.P.; Wawrzynska, M. Functionalized Cardiovascular Stents; Woodhead Publishing: London, UK, 2018. [Google Scholar]
- Williams, A.; Ibrahim, I.T. A new mechanism involving cyclic tautomers for the reaction with nucleophiles of the water-soluble peptide coupling reagent 1-ethyl-3-(3’-(dimethylamino)propyl)carbodiimide (EDC). J. Am. Chem. Soc. 1981, 103, 7090–7095. [Google Scholar] [CrossRef]
- Carbodiimide Crosslinker Chemistry. Available online: https://www.thermofisher.com/tw/zt/home/life-science/protein-biology/protein-biology-learning-center/protein-biology-resource-library/pierce-protein-methods/carbodiimide-crosslinker-chemistry.html (accessed on 3 December 2021).
- Wang, T.-H.; Wu, C.-C.; Huang, K.-Y.; Chuang, W.-Y.; Hsueh, C.; Li, H.-J.; Chen, C.-Y. Profiling of subcellular EGFR interactome reveals hnRNP A3 modulates nuclear EGFR localization. Oncogenesis 2020, 9, 216076896. [Google Scholar] [CrossRef] [PubMed] [Green Version]
- Lin, H.-C.; Chu, L.J.; Huang, P.-J.; Cheng, W.-H.; Zheng, Y.-H.; Huang, C.-Y.; Hong, S.-W.; Chen, L.-C.; Lin, H.-A.; Wang, J.-Y. Proteomic signatures of metronidazole-resistant Trichomonas vaginalis reveal novel proteins associated with drug resistance. Parasites Vectors 2020, 13, 274. [Google Scholar] [CrossRef] [PubMed]

Publisher’s Note: MDPI stays neutral with regard to jurisdictional claims in published maps and institutional affiliations. |
© 2021 by the authors. Licensee MDPI, Basel, Switzerland. This article is an open access article distributed under the terms and conditions of the Creative Commons Attribution (CC BY) license (https://creativecommons.org/licenses/by/4.0/).
Share and Cite
Hu, C.-C.; Kumar, S.R.; Vi, T.T.T.; Huang, Y.-T.; Chen, D.W.; Lue, S.J. Facilitating GL13K Peptide Grafting on Polyetheretherketone via 1-Ethyl-3-(3-dimethylaminopropyl)carbodiimide: Surface Properties and Antibacterial Activity. Int. J. Mol. Sci. 2022, 23, 359. https://doi.org/10.3390/ijms23010359
Hu C-C, Kumar SR, Vi TTT, Huang Y-T, Chen DW, Lue SJ. Facilitating GL13K Peptide Grafting on Polyetheretherketone via 1-Ethyl-3-(3-dimethylaminopropyl)carbodiimide: Surface Properties and Antibacterial Activity. International Journal of Molecular Sciences. 2022; 23(1):359. https://doi.org/10.3390/ijms23010359
Chicago/Turabian StyleHu, Chih-Chien, Selvaraj Rajesh Kumar, Truong Thi Tuong Vi, Yu-Tzu Huang, Dave W. Chen, and Shingjiang Jessie Lue. 2022. "Facilitating GL13K Peptide Grafting on Polyetheretherketone via 1-Ethyl-3-(3-dimethylaminopropyl)carbodiimide: Surface Properties and Antibacterial Activity" International Journal of Molecular Sciences 23, no. 1: 359. https://doi.org/10.3390/ijms23010359
APA StyleHu, C.-C., Kumar, S. R., Vi, T. T. T., Huang, Y.-T., Chen, D. W., & Lue, S. J. (2022). Facilitating GL13K Peptide Grafting on Polyetheretherketone via 1-Ethyl-3-(3-dimethylaminopropyl)carbodiimide: Surface Properties and Antibacterial Activity. International Journal of Molecular Sciences, 23(1), 359. https://doi.org/10.3390/ijms23010359

